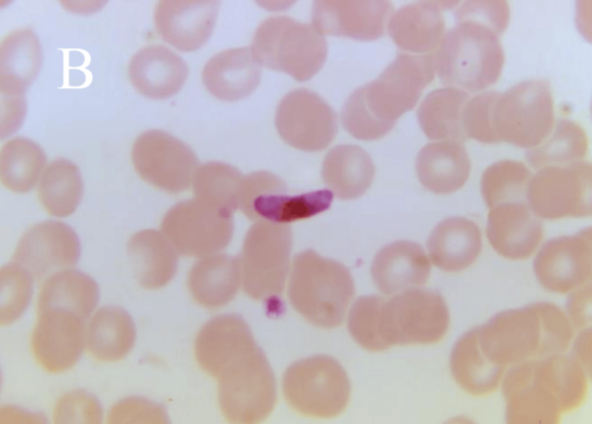

1.疟原虫(Plasmodium)
物种名:疟原虫
拉丁学名:Plasmodium
分类学地位:色藻界Chromista;顶复门Apicomplexa;
无类椎体纲Aconoidasida;血孢子虫目Haemospororida;
疟原虫科Plasmodiidae;疟原虫属Plasmodium
疟原虫属(Plasmodium)是疟疾的病原体。寄生于人体的疟原虫有四种,即间日疟原虫、三日疟原虫、恶性疟原虫和卵形疟原虫。疟原虫通过雌性按蚊叮咬传播,感染脊椎动物(包括人类)的红细胞和肝细胞。其生活史复杂,包括在蚊子体内的有性生殖阶段和在宿主体内的无性生殖阶段。疟原虫感染可引发疟疾,表现为周期性发热、寒战、头痛、贫血等症状,严重时可危及生命。疟疾是全球性公共卫生问题,尤其在热带和亚热带地区流行。
1.1生物学特性
1.1.1生活史
寄生于人体的4种疟原虫生活史基本相同,包括在宿主体内的无性生殖阶段和在蚊子体内的有性生殖阶段。
在人体内的发育分红细胞外期和红细胞内期。红外期,当成熟的孢子经蚊子唾液进入人体,约经30分钟后随血流侵入肝细胞,发育形成红细胞外期裂殖体。等到裂殖子胀破肝细胞后释出,一部分裂殖子被巨噬细胞吞噬,其余部分侵入红细胞,开始红细胞内期的发育。间日疟原虫完成红细胞外期的时间约8天,恶性疟原虫约6天,三日疟原虫为11-12天,卵形疟原虫为9天。侵入红细胞的裂殖子,最后形成含有一定数量裂殖子的成熟裂殖体。红细胞破裂后,裂殖子释出,其中一部分被巨噬细胞吞噬,其余再侵入其他正常红细胞,重复其红细胞内期的裂体增殖过程,经几代红细胞内期裂体增殖后,部分裂殖子侵入红细胞后不再进行裂体增殖而是发育成雌、雄配子体。完成一代红细胞内期裂体增殖,间日疟原虫约需48小时,恶性疟原虫约需36-48小时,三日疟原虫约需72小时,卵形疟原虫约需48小时。4种疟原虫寄生于红细胞的不同发育期,间日疟原虫和卵形疟原虫主要寄生于网织红细胞,三日疟原虫多寄生于较衰老的红细胞,而恶性疟原虫可寄生于各发育期的红细胞[1]。
在蚊子体内的发育开始于雌性按蚊吸食疟疾患者血液,只有雌、雄配子体能在蚊胃内继续发育。雄配子体分裂形成雄配子,与雌配子结合成合子,合子变成动合子,穿过蚊胃壁形成卵囊。卵囊内的细胞分裂产生大量子孢子,子孢子最终集中于按蚊涎腺。当蚊子再次吸血时,子孢子进入人体,开始新一轮发育,引发疟疾。在最适条件下,疟原虫在按蚊体内发育成熟所需时间:间日疟原虫约为9-10天,恶性疟原虫约为10-12天,三日疟原虫约为25-28天,卵形疟原虫约为16天[1]。
1.1.2形态学特征
疟原虫寄生于人体的肝细胞和红细胞内,病原诊断时主要依赖于原虫形态特征及其所寄生的红细胞进行辨别。原虫在红细胞内的形态阶段分为早期滋养体、晚期滋养体、未成熟裂殖体、成熟裂殖体、雌配子体与雄配子体[2]。
(1)早期滋养体:也称环状体。间日疟原虫在此期表现为环较大;核点也较大,偶有2个;红细胞内通常只有一个原虫寄生。恶性疟原虫在此期表现为环小而纤细;有1个或2个核点;环常位于红细胞边缘,呈镶嵌状;红细胞常有多重感染。三日疟原虫在此期表现为环致密;偶有1个以上核点;少见红细胞多重感染。卵形疟原虫在此期表现为环致密;核点明显;红细胞多重感染不常见。
(2)晚期滋养体:间日疟原虫在此期表现为较大,显著的阿米巴样,充满红细胞的大部分;核块状;疟色素显著,棒状;空泡大。恶性疟原虫在此期表现为通常在周围血不可见;大小中等,很少见阿米巴样。三日疟原虫在此期表现为胞质结实,非阿米巴样;常见带状;空泡不显著;疟色素粗糙。卵形疟原虫在此期表现为较小,结实,非阿米巴样;疟色素粗糙,深褐色。
(3)未成熟裂殖体:间日疟原虫在此期表现为大,阿米巴样;核块2个或更多;疟色素细棒状。恶性疟原虫在此期表现为周围血通常不可见;小,结实,许多核块;疟色素单块。三日疟原虫在此期表现为小,结实,核块罕见。卵形疟原虫在此期表现为结实,核分裂成多个;疟色素数量较少。
(4)成熟裂殖体:间日疟原虫在此期表现为通常含12-24个裂殖子;疟色素集中,1-2小团。恶性疟原虫在此期表现为通常在周围血不可见;含8-24个或更多个裂殖子;单个疟色素块。三日疟原虫在此期表现为裂殖子6-12个排成环,充满红细胞;疟色素粗糙,往往趋中分布。卵形疟原虫在此期表现为含4-16个裂殖子较间日疟原虫小。
(5)雌配子体:间日疟原虫在此期表现为圆形或卵圆形;胞质深蓝色,核红结实,偏于一侧;大量疟色素分散。恶性疟原虫在此期表现为新月形;核块趋中;疟色素在核周围较多;胞质着色较雄配子体深。三日疟原虫在此期表现为与间日疟原虫相似,但较小,数量较少;常与同种的滋养体混淆。卵形疟原虫在此期表现为与间日疟原虫相似,但通常较小和数量较少。
(6)雄配子体:间日疟原虫在此期表现为圆形,略大于正常红细胞;胞质淡蓝色、灰色到无色;粉红到紫色核块而疏松;大量深色疟素散布胞质。恶性疟原虫在此期表现为腊肠形;胞质着色较雌配子体浅;核大、疏松、染色淡;疟色素显著散布在胞质内。三日疟原虫在此期表现为与间日疟原虫相似,但较小,数量较少;疟色素较间日疟原虫显著。卵形疟原虫在此期表现为与间日疟原虫相似,但通常较小,数量较少。
图1 疟原虫血涂片显微照片
A:间日疟原虫血涂片显微照片[3],B:恶性疟原虫血涂片显微照片[4]
1.1.3生化特征
疟原虫在人体内发育阶段(红细胞内期)依赖恒定的体温(37℃左右),但蚊体内的发育阶段(孢子增殖期)受环境温度显著影响。按蚊的最适活动温度通常在20-30℃之间,温度过高或过低均会抑制疟原虫在蚊体内的发育。疟原虫在蚊体内的发育需要特定水质条件,极端pH值或污染水体可能影响蚊虫存活,间接抑制疟原虫传播。此外,紫外线、含氯消毒剂、70%乙醇以及高浓度的过氧化氢对环境中的疟原虫消杀具有一定作用。
1.2分布、传播与致病性
1.2.1分布与传播
疟疾在90个国家和地区流行,其传播通常在热带地区全年持续传播,在世界温带地区季节性传播。一个国家内部的传播强度和程度各不相同,可能是局灶性的。疟疾传播风险最高的地区发生在撒哈拉以南非洲和巴布亚新几内亚,在寄生于人体的4种疟原虫中,间日疟原虫在亚热带和温带地区分布最广,恶性疟原虫的分布一般局限在热带,三日疟原虫呈零星分布,而卵形疟原虫主要局限在西非中部和一些南太平洋岛屿[5]。我国疟疾流行于长江流城以南平原和黄淮下游一带及长江以南山区,特别在海南省和云南南部山区多见。我国以间日疟最常见,其次是恶性疟,三日疟和卵形疟少见[6]。疟原虫的传播方式主要是通过具有感染性的雌性按蚊叮咬,还可以通过输血、共用针头、实验室事故、器官移植以及先天性地从母亲传播给胎儿等。
1.2.2致病性
对于从未接触过疟疾的患者,在其血液中检测到疟原虫之前,可能会出现头痛、提光、肌肉酸痛、厌食、恶心,甚至呕吐等症状。而对于既往接触过疟疾的患者,他们在临床症状出现前几天即可在血液中发现疟原虫。
疟疾主要是由于红内期疟原虫所致的感染红细胞的形态与结构的改变,周期性同步化的红细胞破坏与其在相应器官组织内沉淀和所引起的生理、免疫、炎性损伤是疟疾的病理基础。红内期疟原虫寄生在由其虫体诱导的由宿主红细胞膜所形成的纳虫泡内,其虫体活泼、代谢活跃。在感染红细胞膜上还可测到相应的各期虫体蛋白(抗原),引起感染红细胞膜结构与功能的改变,如间日疟、卵形疟感染红细胞上可形成许多薛氏点;尤其是在恶性疟原虫感染的红细胞表面形成的众多小结节,与毛细血管内皮细胞有亲合力,可粘堵重要脏器的毛细血管床,缺血缺氧后可致相应器官组织功能障碍,其中以中枢神经系统最敏感,即恶性脑疟。周期性发作的疟疾病程可以很长,感染红细胞与每个周期可释放的23-25个子代裂殖子及其裂殖体代谢产物释放在血中,可产生多克隆的抗疟抗体和脾大、脾功能亢进,但保护性抗原、抗体的水平并不高[7]。
1.3检测方法
(1)传统方法:血涂片检查法是检测中最常用的方法,通过制作血涂片在显微镜下直观地观察到疟原虫的存在、形态和数量等信息,该法简单直观,成本较低,且能在短时间内完成检测。此外还可以使用血液棕黄层定量分析法,但该法目前只是作为疟疾诊断的一种辅助方法。
(2)免疫学方法:常用的免疫学方法有间接免疫荧光抗体法(IFAT)、酶联免疫吸附试验(ELISA)以及免疫层析技术。其中免疫层析技术主要包括恶性疟原虫富组氨酸蛋白2抗原检测、乳酸脱氢酶抗原检测以及谷氨酸脱氢酶抗原检测[8]。
(3)分子生物学方法:主要有普通PCR、实时荧光定量PCR、DNA探针技术。其中DNA探针技术检测疟原虫是使用一定的示踪物对特定基因序列的核酸片段(探针)进行标记,然后通过探针与待测样本中互补片段的特异性结合,检测判断血样中疟原虫DNA[8]。
1.4典型案例
水资源开发在非洲经济体中变得越来越重要,但尽管改善的水利基础设施具有减轻贫困、促进经济增长、改善粮食安全和减轻洪水的潜力,但疟疾负担确实可能会增加。经过研究调查埃塞俄比亚的Koka水库,发现居住在水库附近的疟疾发病率显著增高,尤其是恶性疟原虫以及间日疟原虫。可能的原因是水库提高了地下水位,促进雨水坑的形成,由此蚊虫可在水坑中发育,最终造成疟疾传播[9]。
1.5防治对策
由于疟原虫的传播方式主要是通过具有感染性的雌性按蚊叮咬,因此蚊媒的防治是预防的重要环节,应采取多种措施清除蚊的滋生场所、杀灭幼虫和成蚊。此外,在进入疟疾流行区之前,可以提前服用抗疟药物。例如,氯喹、乙胺嘧啶或加用磺胺多辛。若不慎被感染,应及时进行治疗,氯喹、奎宁、咯萘啶、羟基哌喹及青蒿素和蒿甲醚等药物对疟疾有一定的治疗成效[6]。
参考文献
- https://baike.baidu.com/item/疟原虫/1229751
- 周庭银, 王明贵, 张文宏, 陈德昌. 血流感染实验诊断与临床诊治 第3版. 上海: 上海科学技术出版社, 2023.
- https://phil.cdc.gov/Details.aspx?pid=29072
- https://phil.cdc.gov/Details.aspx?pid=1373
- Nelson IAH, Bryan PW, Carlos FP et al. An update on prevention of malaria in travelers. Therapeutic advances in infectious disease, 2021, 8: 20499361211040690.
- 陈殿学. 医学免疫学与病原生物学. 上海: 上海科学技术出版社, 2020.
- 刘尔翔, 王恒. 中华医学百科全书: 医学寄生虫学. 北京: 中国协和医科大学出版社, 2023.
- 马赛, 胡薇, 冯茹荔 等. 疟原虫检测技术发展及创新应用探讨. 中国口岸科学技术, 2025, 7: 4-8.
- Jonathan L, Matthew M, Paul K et al. Effect of a large dam on malaria risk: the Koka reservoir in Ethiopia. Tropical Medicine & International Health, 2007, 12: 982-989.
.png)
